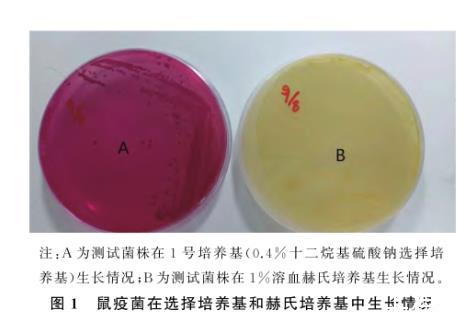

鼠疫耶爾森氏菌在3種選擇培養基生長能力的測定——結果、結論
2結果
2.1鼠疫菌在3種選擇培養基的生長情況及特異性
檢測1號培養基中的鼠疫耶爾森氏菌、假結核耶爾森氏菌和小腸結腸炎耶爾森氏菌生長良好,均為玫紅色菌落,鼠疫菌發育成熟,菌落中心呈淡紅色(見圖1)。金黃色葡萄球菌和鏈球菌不生長,大腸埃希氏菌生長受抑制,菌落計數少。變形桿菌的彌漫性生長受抑制,呈單個菌落;2號培養基可見大腸埃希氏菌生長,其它各實驗菌株生長均受抑制;鼠疫菌在龍膽紫培養基上生長,菌落稍隆起,半透明略帶藍灰色,鏡下觀察鼠疫菌菌落形態不典型,生長緩慢,變形桿菌在龍膽紫培養基上生長受抑制,呈單個菌落,大腸埃希氏菌長滿整個平板。結果見表1。
圖1鼠疫菌在選擇培養基和赫氏培養基中生長情況

表1鼠疫菌在4種培養基生長情況
2.2選擇敏感培養基敏感性的測定
鼠疫菌在龍膽紫培養基和2號培養基敏感性差,鼠疫EV菌液濃度為10-7時,未見鼠疫菌生長,1號培養基在10-8時依然有菌生長,其敏感性與赫氏培養基一致,見表2。

表2鼠疫耶爾森氏菌在各培養基敏感性檢測結果
2.3臟器檢驗結果
應用選擇培養基檢測腐敗材料中鼠疫菌,結果見表3。

表3選擇培養基檢測腐敗材料結果
3結論
鼠疫菌的分離是所有鼠疫預防和控制工作的前提和核心,對于任何從鼠疫監測現場帶回的鼠疫宿主動物或動物遺骸,鼠疫專業人員會盡一切努力分離鼠疫菌,并保存鼠疫菌種,分離鼠疫菌的基礎是選擇適合的培養基并能快速挑選目的菌。傳統分離鼠疫基礎培養基是赫氏培養基,鼠疫菌在赫氏培養基上通過低倍顯微鏡能見灰白色小菌落,鏡下可見菌落中心隆起、表面有黃褐色粗糙顆粒,邊緣不整齊呈薄而透明的花邊狀,為典型鼠疫菌成熟菌落形態,這需要專業人員憑豐富的經驗、扎實的專業知識來辨別鼠疫菌并根據鼠疫菌噬菌體裂解實驗來確定鼠疫菌。但在實際工作中,由于鼠疫菌在不同因素影響下其形態表現為多樣性;自然界存在不被噬菌體裂解的鼠疫菌,因此僅從菌落形態及噬菌體裂解實驗進行判斷易漏診。本研究是結合鼠疫菌特異性酶的特征,在赫氏消化液基礎上研制鼠疫菌選擇敏感培養基,這其中,赫氏消化液用于增菌,1號培養基含0.5%膽鹽,具有高度特異性,含有甘露醇同時具有鑒別作用。
通過對3種選擇培養基敏感性和特異性檢測,可以看出3種選擇培養基中,龍膽紫培養基和1號培養基對鼠疫菌的生長和選擇能達到基本檢出的要求,1號培養基可以檢出10-1個菌/m L,敏感性高于龍膽紫培養基,與基礎培養基無統計學差異(P值和統計方法)。鼠疫菌株在1號培養基經28℃培養24 h即可生長發育成熟,菌落呈玫紅色,具備鼠疫菌典型結構(菌落花邊大,中央顆粒粗糙),變形桿菌、大腸埃希氏菌及革蘭氏陽性桿菌生長均受抑制,結果顯示該培養基特異性好。龍膽紫培養基是分離鼠疫菌常用選擇性培養基,可以抑制變形桿菌和革蘭氏陽性菌,但大腸埃希氏菌在該培養基上生長良好,并且抑制鼠疫菌的正常生長,據此龍膽紫選擇培養基在野外污染嚴重材料的鼠疫菌培養中應用不理想,只適于實驗室動物感染試驗或污染不嚴重時鼠疫菌的分離,例如在鼠疫菌的毒力測定等實驗,鼠疫菌在2號培養基生長發育差,菌落呈灰白色,與其它雜菌不易區分,不適于鼠疫菌分離培養。
3種選擇培養基應用于動物疫情的檢測,1號培養基與龍膽紫培養基的檢出結果符合率為100%。由于野外動物材料腐敗,其中01和04旱獺只剩股骨殘骸,對照培養基各臟器變形桿菌彌漫性生長,覆蓋少許鼠疫菌,導致分離困難,應用1號選擇培養可抑制變形桿菌彌漫性生長,玫紅色鼠疫菌生長良好,極易挑選。龍膽紫培養基上鼠疫菌亦可檢出,但生長緩慢,培養24~48 h依然為初級菌落。狗臟器培養顯示攜帶噬菌體合并雜菌污染,赫氏培養基上無法挑選鼠疫菌,通常需應用抗噬菌體血清培養基分離鼠疫菌,但在野外無法制備,本研究應用1號選擇敏感培養基,鼠疫菌24 h發育成熟,菌落呈玫紅色,結構典型,能抑制雜菌生長,鼠疫菌易于挑選,不足之處在于鼠疫菌分離后依然攜帶噬菌體,所以分離后需在專業實驗室進行抗噬菌體血清培養基進一步分離培養后菌株方能保存。實際檢測可看出1號培養基效果優于龍膽紫培養基。
01號培養基是筆者自主研發的顯色培養基,該培養基是利用顯色培養基的原理,使用中性紅為顯色底物,在鼠疫菌特異性酶作用下酵解甘露醇產酸,中性紅指示劑在酸性環境中產生紅色集團附著于菌落上,使鼠疫菌菌落顯示紅色,同時添加抑制變形桿菌和革蘭氏陽性菌的試劑,十二烷基硫酸鈉,紅霉素,膽鹽3號,阿莫西林,對變形桿菌、大腸桿菌和革蘭氏陽性菌抑制作用強,適用于檢驗腐敗和雜菌污染的動物材料,而且生長的鼠疫菌菌落典型,易于挑選,在野外材料鼠疫菌分離有實際意義,使用該培養基應注意耶爾森氏菌屬中與鼠疫菌近源的假結核桿菌、小腸結腸炎菌都具有能發酵甘露醇的特異性酶,在實際應用中分離疑似菌后應做噬菌體裂解實驗和鼠疫核酸檢測以確證。
